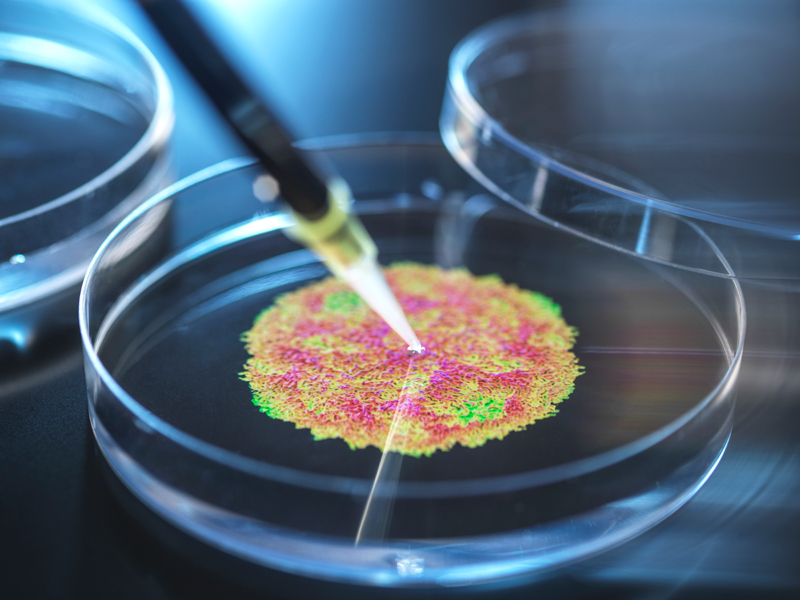
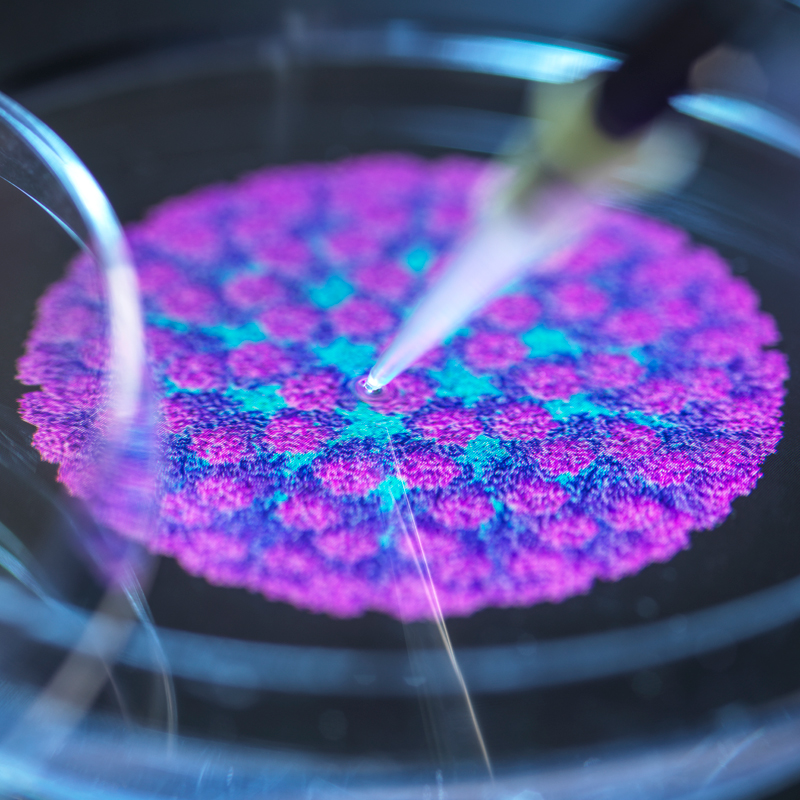

Technology
면역세포분석
유세포 분석이란?
유세포 분석(Flow Cytometry)은 형광 항체를 이용해 단일 세포 수준에서 다양한 단백질 발현을 동시에 정량 측정할 수 있는 정밀 분석 기술입니다.

젬바이오사이언스의 유세포 분석
-
1. 인간화 마우스에 최적화된 분석 프로토콜
기존 마우스와는 다른 면역 구조를 가진 인간화 마우스를 위한 맞춤형 패널을 구성하여 면역 반응을 정밀 분석합니다.
-
2. 고해상도 다중 형광 분석 시스템 보유
최대 21채널 이상의 형광 분석이 가능한 시스템을 보유하고 있어, 다양한 면역세포를 동시에 분석할 수 있습니다.
-
3. 면역세포 기능 분석 가능
단순한 표면 마커 분석을 넘어, 사이토카인 발현, 세포증식 및 세포사멸 등의 지표까지 측정하여 면역세포의 상태와 기능을 통합적으로 평가합니다.
-
4. 전문 분석 인력 및 맞춤형 서비스
면역학 및 유세포 분석에 풍부한 경험을 가진 연구진이 실험 설계부터 분석까지 전 과정을 맞춤형으로 지원합니다.
